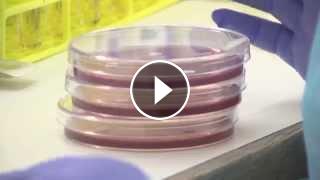

516
צפיות
- קטגוריה
- רפואה ובריאות מחלות מערכת העיכול
סרטונים נוספים
-
תעוקת לב ו התקף לב: תסמינים ודרכי אבחון
מאת vod-galit 451 צפיות -
וירוס ה HCV והפטיטיס C: תסמינים ודרכי אבחון
מאת vod-galit 841 צפיות -
אוסטאופורוזיס: תסמינים ודרכי אבחון
מאת vod-galit 720 צפיות -
שבץ מוחי: תסמינים ודרכי אבחון
מאת vod-galit 470 צפיות -
קוליטיס כיבית: תסמינים ודרכי אבחון
מאת vod-galit 451 צפיות -
דלקת ריאות: תסמינים ודרכי אבחון
מאת vod-galit 464 צפיות -
מחלת כליות כרונית: תסמינים ודרכי אבחון
מאת vod-galit 448 צפיות -
דלקת מפרקים של גיל הילדות: תסמינים ודרכי אבחון
מאת vod-galit 399 צפיות -
פסוריאזיס (ספחת): תסמינים ודרכי אבחון
מאת vod-galit 738 צפיות -
אקנה: תסמינים ודרכי אבחון
מאת vod-galit 879 צפיות -
שרירנים ברחם: תסמינים, אבחון ודרכי טיפול
מאת vod-galit 1,015 צפיות -
וירוס ה RSV וברונכיוליטיס: תסמינים ודרכי אבחון
מאת vod-galit 635 צפיות -
עיצוב צמות לילדות
מאת vod-galit 4,974 צפיות -
סודות בתאריך הלידה, משמעות חודש הלידה - ינואר זינה ליבשיץ נומרולוגית
מאת vod-galit 3,948 צפיות -
רנה רז-גילו - נומרולוגית - ייעוץ אישי און-ליין- נומרולוגית בגבעת שמואל
מאת Shahar-vod 2,638 צפיות -
יוסי שר - מתמחה בשיטת אלכסנדר וטאי צ'י ברחובות ובקיבוץ נען
מאת Shahar-vod 2,851 צפיות -
איך לטפל בכבד שומני וטריגליצרידים גבוהים בדם
מאת vod-galit 3,047 צפיות -
מירב מתן - רפואת תדרים וביו אנרגיה באלעד - האם באמת הכל בראש שלנו?
מאת Shahar-vod 2,395 צפיות -
תסרוקות לבית ספר-מגוון שיטות לקליעת צמות לילדות HAIR STYLING
מאת vod-galit 38k צפיות -
לנה שסטקוב - טיפול בכאבי גב בירושלים - כלים לחיים בריאים, איזון וריפוי גוף נפש
מאת Shahar-vod 2,856 צפיות -
אורלי שטיינבך - פסיכותרפיה גופנית ודמיון מודרך בתל אביב- כלים של תמיכה ומגע עצמי לשחרור מתחים - 2
מאת Shahar-vod 2,639 צפיות -
אורלי שטיינבך - פסיכותרפיה גופנית ודמיון מודרך בתל אביב- תרגילי הרפיה להפחתת מתחים - וידיאו 3
מאת Shahar-vod 2,404 צפיות -
מירב מתן - רפואת תדרים וביו אנרגיה באלעד - חרדה (1)
מאת Shahar-vod 2,499 צפיות -
מירב מתן - רפואת תדרים וביו אנרגיה באלעד - איך נראה אומץ?
מאת Shahar-vod 2,406 צפיות